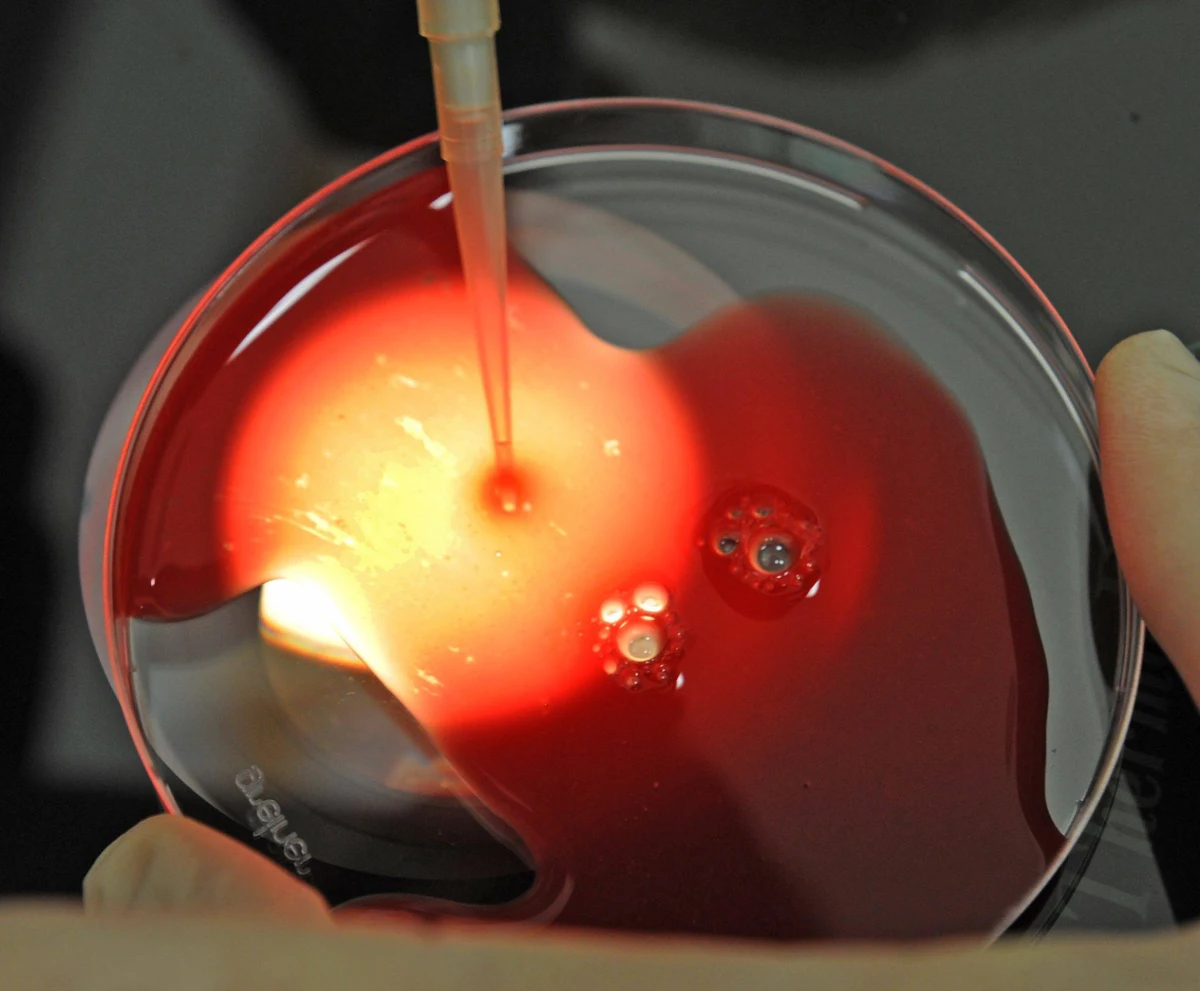
Za odrzuceniem ustawy o in vitro opowiedziała się w czwartek senacka komisja zdrowia, przyjmując najdalej idący wniosek spośród zgłoszonych podczas debaty. W związku z tym komisja nie rozpatrywała poprawek zgłoszonych do ustawy. W piątek Senat będzie głosował ws. ustawy o in vitro. Marszałek Borusewicz jest przekonany, że senatorowie ustawę przyjmą.

Za odrzuceniem ustawy o in vitro opowiedziała się w czwartek senacka komisja zdrowia, przyjmując najdalej idący wniosek spośród zgłoszonych podczas debaty. W związku z tym komisja nie rozpatrywała poprawek zgłoszonych do ustawy. W piątek Senat będzie głosował ws. ustawy o in vitro. Marszałek Borusewicz jest przekonany, że senatorowie ustawę przyjmą.
Komisja zebrała się w czwartek wieczorem, by zająć się poprawkami i wnioskami zgłoszonymi podczas 14-godzinnej debaty nad ustawą o in vitro, która odbyła się dzień wcześniej.
Najpierw głosowano wniosek najdalej idący, czyli o odrzucenie ustawy. Ten wniosek poparło 4 senatorów; jeden był przeciwko; 5 - wstrzymało się od głosu. Senacka komisja zdrowia liczy 11 senatorów (siedmioro z PO; czworo z PiS).
W związku z poparciem wniosku PiS o odrzucenie ustawy komisja nie zajęła się zgłoszonymi podczas debaty poprawkami do ustawy. Zgłaszali je senatorowie PO, PiS, PSL i z Koła Senatorów Niezależnych.
Bogdan Pęk (PiS) zgłosił poprawkę do tytułu, aby zamiast "o leczeniu niepłodności", ustawa nazywała się: "o pozaustrojowym zapłodnieniu in vitro".
Poprawki zgłoszone przez senator PO Helenę Hatkę miały m.in. poprawić definicję zarodka, ograniczyć liczbę zarodków do dwóch, oddzielić ośrodki leczenia niepłodności od tych stosujących procedurę in vitro.
Poprawkę zmierzającą m.in. do finansowania procedury in vitro wyłącznie dla małżeństw zgłosili senatorowie Andżelika Możdżanowska, Józef Zając (oboje z PSL), Jan Filip Libicki (PO) i Jarosław Obremski (Koło Senatorów Niezależnych).
W czwartek list do marszałka Senatu Bogdana Borusewicza skierowała Kancelaria Prezydenta. W piśmie stwierdzono, że wprowadzana ustawą o in vitro możliwość pobierania komórek rozrodczych od dawcy, który jest niezdolny do świadomego wyrażenia zgody, budzi poważną wątpliwość, co do zgodności z konstytucją i prawem międzynarodowym.
W odpowiedzi na to pismo Borusewicz oświadczył w TVP Info, że prezydent może skierować ustawę do Trybunału Konstytucyjnego po jej podpisaniu, jeśli ma wątpliwości co do jej konstytucyjności.
Marszałek jest przekonany, że w piątek Senat przyjmie ustawę. Będę głosował za tą ustawą z pełnym przekonaniem. To jest ustawa, która bierze w karby to, co się dzieje w tej dziedzinie - powiedział. W jego ocenie ci, którzy protestują przeciwko ustawie, nie zdają sobie sprawy, że w tej chwili "można wszystko robić z zarodkami".
Ustawę o leczeniu niepłodności, w tym metodą pozaustrojowego zapłodnienia in vitro, Sejm uchwalił pod koniec czerwca. Daje ona prawo do korzystania z niej małżeństwom i osobom we wspólnym pożyciu, potwierdzonym zgodnym oświadczeniem. Leczenie niepłodności tą metodą będzie mogło być podejmowane po wyczerpaniu innych metod leczenia, prowadzonych przez co najmniej 12 miesięcy. Ustawa zezwala na dawstwo zarodków, zabrania zaś ich tworzenia w celach innych niż pozaustrojowe zapłodnienie. Zakazuje też niszczenia zarodków zdolnych do prawidłowego rozwoju - grozić będzie za to kara pozbawienia wolności od 6 miesięcy do lat 5.
O nieprzyjęcie ustawy ponownie zaapelował do senatorów episkopat.
(j.)